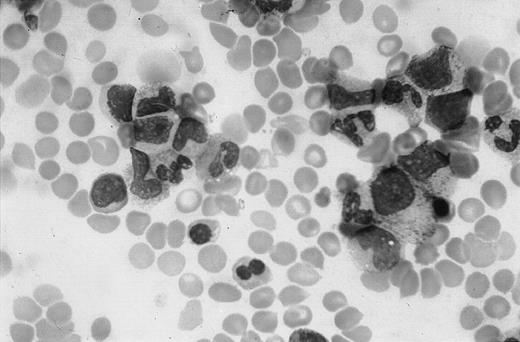
Fig. 1. Bone marrow appearance on admission. / Marked decrease of nucleated erythroid cells with binucleate erythroblasts, absence of megakaryocyte, and normal myeloid cells. Magnification, × 1000.

Abstract
Vitamin A is a pivotal biochemical factor required for normal proliferation and differentiation as well as for specialized functions, such as vision. The dietary intake of 1500 IU/day is recommended in the first year of life. Here, we report the case of an infant who had been given 62 000 IU/day for 80 days. The infant showed several clinical signs of retinol intoxication, including severe anemia and thrombocytopenia. Bone marrow showed a remarkably reduced number of erythroid and megakaryocytic cells. The interruption of vitamin A treatment was immediately followed by clinical and biochemical recovery. To clarify whether the effects of retinol are due to a direct action on bone marrow cell proliferation, we investigated the activity of retinol (both the drug and the pure molecule) on the growth of K-562, a multipotent hematopoietic cell line, and on bone marrow mesenchymal stem cells. We observed that vitamin A strongly inhibited the proliferation of the cells at concentrations similar to those reached in vivo. Subsequent biochemical analyses of the cell cycle suggested that the effect was mediated by the up-regulation of cyclin-dependent kinase inhibitors, p21Cip1 and p27Kip1. These are the first findings to demonstrate that infant hypervitaminosis A causes a severe anemia and thrombocytopenia and that this is probably due to the direct effect of the molecule on the growth of all bone marrow cellular components. Our data also suggest potential bone marrow functional alterations after excessive vitamin A intake because of emerging social habits.
Introduction
Vitamin A (all-trans-retinol), a fat-soluble vitamin, is an essential nutrient for humans because it cannot be synthesized de novo. The molecule is involved in all normal cellular proliferation and differentiation processes. Particularly, vitamin A and some of its derivatives are required for several processes, including embryogenesis, vision, reproduction, skeletal development, and maintenance of epithelial tissues. The vitamin is stored primarily in the liver and is transported in plasma bound to a specific protein, ie, the retinol-binding protein (RBP).1
Toxicity appears to occur only when the amount of vitamin A exceeds the binding capability of RBP. In addition, retinol has a long biologic half-life and bioaccumulates. The combination of relatively rapid absorption with a low clearance can produce acute toxicity within hours after a sufficiently high dose and chronic toxicity after prolonged intake of substantially smaller doses.2
Hypervitaminosis A has been observed in both children and adults. The presentation of adverse symptoms varies with the dose and the duration of exposure as well as with the age of the individual. In particular, in the first months of life the clinical picture of retinol intoxication differs from other periods of life, and a correct diagnosis may, therefore, be difficult.2,3 The recommended dietary intake in the first year of life is 1500 IU/day. Children can be intoxicated by total daily intakes of vitamin A lower than those necessary to cause adverse effects in adults. In children, however, hypervitaminosis develops quickly and usually resolves quickly. In most cases, when the intake is discontinued, many symptoms are relieved within about a week, and full recovery usually follows within weeks or months.2 3
In this study, we describe the case of an infant with a chronic vitamin A intoxication. A pivotal clinical symptom was severe anemia and thrombocytopenia. This observation prompted us to investigate the in vitro effect of the drug used and pure all-trans-retinol on experimental models representing the various bone marrow cellular populations.
The complex cellular array present in bone marrow contains stem cells of both hematopoietic and nonhematopoietic lineages. The cells of this latter lineage are referred to as mesenchymal stem cells or marrow stromal cells (MSCs) and are multipotential, because they can give rise to precursors for bone marrow stroma, bone, cartilage, and adipose tissue.4 In addition to being progenitors of connective tissue, under an appropriate microenvironment and stimuli, MSCs can differentiate into myogenic precursors.5 Furthermore, it has recently been shown that MSCs can overcome their mesenchymal commitment and differentiate into neural cells and express neuron-specific markers.6 7
The hematopoietic and nonhematopoietic stem cells not only coexist in the bone marrow but also functionally cooperate and are strictly dependent on each other. In particular, a series of studies has suggested the importance of cytokine production and cell-cell contact by MSCs in the growth and survival of hematopoietic cells.8-10 The stromal cell compartment produces not only matrix proteins but also the essential growth factors, which initiate and support the differentiation of primary quiescent, but eventually activated, CD34− stem cells into CD34+ hematopoietic progenitors.11
Patient, materials, and methods
Patient
A 3-month-old white boy with unrelated parents was admitted to the Department of Pediatrics, 2nd University of Naples, for further investigation of anemia and thrombocytopenia. He had severe normochromic-normocytic anemia with a hemoglobin level of 59 g/L, a mean cell volume of 98 fL, and a mean cell hemoglobin concentration of 310 g/L; the reticulocyte count was 8 × 109/L; the leukocyte count was 6.2 × 109/L with lymphocytes 74%, neutrophils 17%, eosinophiles 3%, and monocytes 6%; the platelet count was 30 × 109/L. The blood smear showed anisopoikilocytosis.
The child was born from a normal delivery. Birth weight was 2700 g, length 49 cm, and head circumference 32 cm. Dietary history included artificial nursing with prepared formulas. The patient had been well until 10 days earlier, when he became anorexic and feverish. He had no history of preceding viral illness or exposure to toxins associated with bone marrow suppression. Physical examination revealed an extremely pale child who was very irritable with signs of increased cardiac output (tachycardia and systolic murmur), bulging anterior fontanel, dry itchy skin with petechiae, angular fissures of the lips, and hepatosplenomegaly. The liver edge was 6 cm below the right costal margin, and the spleen edge was 9 cm below the left costal margin. Standard measurements were length 62 cm (50th-75th percentile), weight 5200 g (10th-25th percentile), and head circumference 45 cm (>97th percentile). Neurologic examination was normal with physiologic optic discs. Bone marrow aspiration showed a markedly reduced erythroid cellularity with evidence of dyserythropoiesis in the form of vacuolated or binucleate erythroblasts and an almost complete absence of megakaryocytes (Figure 1). No atypical myeloid or lymphoid cells were seen. Serum bilirubin and haptoglobin levels, hemoglobin electrophoresis, erythrocyte enzyme levels, osmotic fragility with incubated and nonincubated erythrocytes were normal. Serum iron levels were high (36.66 mM/L), probably because of decreased utilization. Aspartate transaminase, alanine transaminase, and γ-glutamyl transpeptidase were slightly increased (data not shown). Direct and indirect Coombs tests, i-antigen expression on the erythrocyte surface, and the Ham test were negative. Karyotype analysis of bone marrow and peripheral blood cells revealed a normal male pattern without significant spontaneous or diepoxybutane-induced chromosomal breakages. There was no serologic evidence of Epstein-Barr virus, human cytomegalovirus, human immunodeficiency virus, or hepatitis virus infection. No immunoglobulin (Ig)G or IgM antibodies to parvovirus B19 were found in serial measurement. Chest x-ray findings were normal. Abdominal ultrasound was normal except for hepatosplenomegaly.
Bone marrow appearance on admission.
Marked decrease of nucleated erythroid cells with binucleate erythroblasts, absence of megakaryocyte, and normal myeloid cells. Magnification, × 1000.
Bone marrow appearance on admission.
Marked decrease of nucleated erythroid cells with binucleate erythroblasts, absence of megakaryocyte, and normal myeloid cells. Magnification, × 1000.
A detailed questioning on drug ingestion revealed that the child had been given 12 gtt/day of Arovit (an aqueous solution of vitamin A palmitate; Roche, Italy) since the 10th day of his life because of misinterpretation of the pediatrician's prescription. Thus, the total daily retinol ingested was about 62 000 U formed by 60 000 U from Arovit plus the vitamin A contained in the prepared formulas. This treatment lasted for about 80 days.
Increased levels of the unbound retinol resulting in high levels of retinyl esters12 as well as a raised retinol/RBP ratio were found (Table 1). On the basis of these findings a diagnosis of chronic hypervitaminosis A was made, and the vitamin was immediately discontinued. Fifteen days after drug interruption, the hemoglobin level and platelet count rose to 76 g/L and to 105 × 109/L, respectively. The reticulocyte count increased from 8 to 300 × 109/L (Table 1). The bone marrow examination performed 1 month after stopping vitamin ingestion showed a normal population of erythroid and myeloid cells as well as of megakaryocytes (data not shown). The retinyl esters were reduced by about 80% after 3 months (Table 1). The liver and spleen returned to normal size after 6 months. Now, after 3 years, the child is in good health with normal complete blood count and normal psychomotor development.
Cellular models
Because bone marrow hematopoietic and nonhematopoietic components are interdependent, we chose experimental models to evaluate the in vitro vitamin A effect, which represents both these components.
We used 2 primary MSC preparations from the bone marrow of a 5-year-old and a 7-year-old child and K-562, a human erythroleukemia cell line, which is multipotential and can differentiate into recognizable progenitors of the erythrocytic, megakaryocytic, granulocytic, and monocytic series.13-16 Approval was obtained from the institutional review board for these studies. Informed consent was provided according to the Declaration of Helsinki.
The preparation of MSCs was performed as previously reported by Friedenstein et al17 with some modifications. Briefly, a 2-mL sample of heparinized human bone marrow was diluted 1:2.5 with Opti-MEM (Life Technologies, Gaithersburg, MD), a serum-free medium containing penicillin (100 U/mL) and streptomycin (100 μg/mL), placed in 100-mm polystyrene dish, and incubated at 37°C in a 5% CO2 humidified atmosphere. After 24 hours, the medium was collected and centrifuged at 800g. Half of the supernatant (conditioned medium, CM) was aspirated, added to an equal volume of fresh medium, and placed in the first plate. The medium remaining in the tube was used to resuspend the cellular pellet, and, after the addition of an equivalent volume of fresh culture medium, the entire cellular suspension was plated in a second dish. The day after, the medium of the 2nd plate was also centrifuged: the pellet, containing all nonadherent cellular elements, was discarded, and the corresponding CM was added again to the dish. After 3 to 4 days, a limited number of small foci of adherent fibroblastlike cells began to appear and develop until colonizing the entire dish surface in 2 to 3 weeks. During this period, fresh medium was added every 3 days, without ever removing the CM. After reaching confluence, cells were trypsinized and plated at a density of 5 × 103 cm−2, always diluting the conditioned medium. Cultures between the 3rd and 6th passages were used in our experiments.
K-562 cells were grown in RPMI 1640 supplemented with 10% heat-inactivated fetal calf serum and penicillin-streptomycin.18
Cell treatments
All-trans-retinol was obtained from Sigma Chemical Company (St Louis, MO), resuspended in dimethylsulfoxide at a concentration of 87 mM and stored at −80°C. In the experiment with the vitamin A, the molecule was directly added to cell cultures at the indicated concentrations, whereas control cells contained the solvent alone. For the Arovit investigations, we assumed that 1 μMconcentration corresponded to 1.4 IU/mL. Moreover, to sterilize the solution, culture media containing the drug were filtered before use.
About 3 × 105/mL K-562 cells were incubated with or without the indicated amounts of the molecules, and the growth of cells was evaluated by counting them daily. These experiments were performed in 25-cm−2 flasks containing 5 mL of cells. MSC preparations were plated at a density of 5 × 103cm−2 in 100-mm dishes.
Experiments were carried out to verify the reversibility of vitamin A–dependent growth inhibition: K-562 cells were incubated with 40 μM vitamin A for 48 hours, then the cells were centrifuged and resuspended in fresh medium. Subsequently, the proliferation rate was evaluated and compared with that of control cells.
The hydrolysis of polyADPribose polymerase, an early biochemical marker of apoptosis, was determined as described in Della Ragione et al.19
Preparation of cell extracts, immunoblotting, and kinase assay
Cell extracts were prepared as described previously.18-20 Cell extracts (10-80 μg) were analyzed by sodium dodecyl sulfate–polyacrylamide gel electrophoresis by using different percentages of acrylamide-resolving gel, transferred to a nitrocellulose membrane, and incubated with different antisera.18 The immunocomplexes were detected by the alkaline phosphatase method or by the enhanced chemoluminescent technique (Amersham, Bucks, United Kingdom) as previously described.18-20
Cdk2 activity was evaluated as follows: 500 μg of cell extracts was mixed with the specific antibody for 2 hours at 4°C, and the immunocomplexes were precipitated by protein A-agarose (1 hour at 4°C). The pellets were then washed and assayed for cdk2 activity by using histone H1 as substrate.21
Monoclonal antibodies to cyclin A and cyclin E were provided from Santa Cruz Biotechnologies (Santa Cruz, CA). Monoclonal antibodies to p21Cip1 were from PharMingen, (San Diego, CA), whereas those to p27Kip1 were from Transduction Laboratories (Lexington, KY). Polyclonal antibodies to cdk2, cdk4, cdk6, cyclin D1, cyclin D2, and cyclin D3 were from Santa Cruz Biotechnologies.
Results
The effect of increasing amounts of Arovit and vitamin A is shown on the growth of K-562 cells in Figure2A,B and of MSCs in Figure3A,B. The range of concentrations used (from 20-80 μM) corresponds to the likely in vivo value, taking into account the daily uptake of the drug (62 000 units, 44 μmol), the weight of the infant (about 4 Kg), and the well-known tissue accumulation of the lipophilic vitamin. The concentration of vitamin A in Arovit was determined by assuming that 1 μM corresponds to 1.4 IU/mL.
Effect of Arovit and vitamin A on the growth of K-562 cells.
(A) K-562 cells were plated at 300 000 cells/mL and incubated with or without different Arovit or vitamin A amounts. At the reported time intervals, the cell number was determined. The data shown represent the mean of 3 independent experiments, each performed in duplicate. (B) Morphologic appearance of K-562 incubated for 48 hours with (i) or without (ii) 80 μM vitamin A.
Effect of Arovit and vitamin A on the growth of K-562 cells.
(A) K-562 cells were plated at 300 000 cells/mL and incubated with or without different Arovit or vitamin A amounts. At the reported time intervals, the cell number was determined. The data shown represent the mean of 3 independent experiments, each performed in duplicate. (B) Morphologic appearance of K-562 incubated for 48 hours with (i) or without (ii) 80 μM vitamin A.
Effect of Arovit and vitamin A on the growth of MSCs.
(A) MSCs were plated at a density of 5 × 103cells/cm−2 and incubated with or without different Arovit or vitamin A amounts. At the reported time intervals, the cell number was determined. The data shown represent the mean of 3 independent experiments, each performed in duplicate. (B) Morphologic appearance of MSCs incubated for 72 hours with (i) or without (ii) 80 μM vitamin A.
Effect of Arovit and vitamin A on the growth of MSCs.
(A) MSCs were plated at a density of 5 × 103cells/cm−2 and incubated with or without different Arovit or vitamin A amounts. At the reported time intervals, the cell number was determined. The data shown represent the mean of 3 independent experiments, each performed in duplicate. (B) Morphologic appearance of MSCs incubated for 72 hours with (i) or without (ii) 80 μM vitamin A.
Arovit potently inhibits K-562 proliferation when added to the culture medium (Figure 2A). The same effect was obtained with pure vitamin A (Figure 2A). These data suggest that the biologic activity of the drug on cell proliferation is due to its vitamin A content. Moreover, the addition of retinol did not significantly modify the morphology of the cells (Figure 2B). Finally, incubation of cells with retinol did not cause a definite growth arrest. Indeed, when the cells were incubated for 48 hours with 40 μM vitamin A and then the drug was removed, a normal rate of proliferation occurred (data not shown). These results indicate that, under the conditions used, the inhibition of growth was powerful but rapidly reversible and that the molecule interferes, not irreversibly, with molecular process(es) required for cell proliferation.
Subsequently, we investigated the effect of Arovit and vitamin A on the growth of primary cultures of MSCs established from the bone marrow of 2 children (Figure 3 and data not shown). Figure 3A demonstrates that the proliferation rate of the cellular population (prepared from a 5-year-old child) is noticeably, and almost equally, affected by the pure molecule and the commercial drug. Interestingly, a high dosage of Arovit (120 μM) completely inhibits the cell growth. Because these concentrations can be reached in vivo, the effect of the molecule is remarkably important. Completely identical findings were obtained by using an MSC population established from the bone marrow of a 7-year-old child (data not shown).
The cell growth inhibition seems to be unrelated to the activation of the apoptotic process. Indeed, we found no morphologic alteration on microscopy analysis (Figures 2B and 3B). Moreover, biochemical analysis of polyADPribose polymerase hydrolysis, an early marker of activated apoptotic process, confirmed the absence of programmed cell death activation (data not shown).
Next, we analyzed the effect of vitamin A on the cell cycle. Particularly, we investigated the content of cyclin E, cyclin A, cdk2, cdk4, p21Cip1, and p27Kip1 in MSCs treated for 2 days with 40 μM Arovit or vitamin A. This study provides data on the molecular mechanism(s) responsible for the antiproliferative effect and also characterizes the precise cellular phase affected by the molecules. As shown in Figure 4A, an increase of p27Kip1 and p21Cip1 from 2- to 3-fold was observable, thus suggesting that the activity of the compounds is due to the accumulation of cyclin-dependent kinase inhibitors. Conversely, the cdk2 and cdk4 content did not vary (data not shown).
Analysis of the cell cycle in vitamin A– and Arovit-treated MSCs.
(A) Cyclin E, cyclin A, p27Kip1, p21Cip1, and actin immunoblotting analyses of 48 hours of vitamin A–treated MSCs. The concentration of all-trans-retinol used in the experiment was 40 μM. Protein (20 μg) was used for actin, cyclin, and p27Kip1immunoblotting, whereas 80 μg protein was used for p21Cip1. At the bottom of each immunoblot the relative amount of the signals (control is assumed as 1.0) determined by laser scanning. (B) Cdk2 was immunoprecipitated from equal amounts of cellular extracts (500 μg) as reported in “Patient, materials, and methods.” Identical aliquots of the immunoprecipitated materials were assayed for the kinase activity (Cdk2 activity) and for the cdk2 total contents by immunoblotting (Cdk2).
Analysis of the cell cycle in vitamin A– and Arovit-treated MSCs.
(A) Cyclin E, cyclin A, p27Kip1, p21Cip1, and actin immunoblotting analyses of 48 hours of vitamin A–treated MSCs. The concentration of all-trans-retinol used in the experiment was 40 μM. Protein (20 μg) was used for actin, cyclin, and p27Kip1immunoblotting, whereas 80 μg protein was used for p21Cip1. At the bottom of each immunoblot the relative amount of the signals (control is assumed as 1.0) determined by laser scanning. (B) Cdk2 was immunoprecipitated from equal amounts of cellular extracts (500 μg) as reported in “Patient, materials, and methods.” Identical aliquots of the immunoprecipitated materials were assayed for the kinase activity (Cdk2 activity) and for the cdk2 total contents by immunoblotting (Cdk2).
It is well known that the accumulation of p27Kip1 and p21Cip1 can block either G1→S or S→G2 phase transition. The analysis of cyclin levels revealed increased cyclin E and A contents (Figure 4). This finding suggests that the vitamin A–dependent proliferation arrest mainly occurs by an extended S phase and/or by an interference at the G2 checkpoint.22-24
To directly evaluate the effect of p27Kip1 and p21Cip1 accumulation on cyclin-dependent kinase activity, Cdk2 was immunoprecipitated from cellular extracts and assayed for the enzymatic activity. As shown in Figure 4B, a remarkable decrease of the kinase activity, but not of protein, was evidenced, thus confirming the functional effect of the increase of the 2 inhibitors.
Discussion
The picture of chronic hypervitaminosis A is highly variable, but anorexia, dry itchy skin, alopecia, bone pain, increased intracranial pressure, and hepatosplenomegaly are the most common manifestations.2,3 Anemia has been seldom observed,2,25 whereas thrombocytopenia has been reported in only 2 cases.26 27 Moreover, a relationship between vitamin A intoxication and bone marrow failure has never been suggested.
Chronic hypervitaminosis A has been described in children during the first half year of life.28 The toxic doses of vitamin A were 18 000 to 60 000 IU/day, and the period of overdosing was from 1 to 2 months. These children showed mild to severe anemia with normal platelet and white blood cell count. However, because the patients contemporaneously introduced both vitamin A and D, the effects of a single vitamin was not clearly identifiable. The picture is also complicated by the observation that animal studies indicate that vitamin D diminishes the toxic effects of vitamin A and vice versa.29 Moreover, the vitamin A in these cases was dispersed in oil solution. Lewis et al30 showed in infants that an aqueous dispersion induced a 4-fold increase in blood concentration and a smaller fecal loss of vitamin A compared with oil preparation.
In our case, the 3-month-old infant was erroneously treated with a high dose (62 000 IU/day) of vitamin A in aqueous solution for about 3 months. To the best of our knowledge, this is the first example of anemia and thrombocytopenia because of chronic intoxication of vitamin A. The close temporal relationship between suspension of vitamin A intake and the bone marrow recovery clearly suggests that the renewed functionality of hematopoiesis was strictly related to the interruption of vitamin A treatment.
To investigate the relationship between hypervitaminosis A and anemia/thrombocytopenia, we have performed in vitro studies on cellular models. We observed that retinol (both Arovit and the pure molecule), at concentrations similar to those reached in vivo during the chronic vitamin intoxication, inhibited the proliferation of a multipotent hematopoietic cell line, namely K-562. Because the cell line might give origin to both erythrocytes and megakaryocytes,13-16 the data obtained could explain the severe anemia and thrombocytopenia. Further experiments demonstrated that the growth of primary cultures of MSCs was also remarkably down-regulated by retinol. It is important to underline that MSCs regulate proliferation and differentiation of several hematopoietic lineages.8-10 Thus, the antiproliferative effect of vitamin A on MSCs might result in a general bone marrow function impairment. The activity of retinol is completely reversible, thus suggesting that the vitamin does not induce apoptosis and/or an irreversible commitment to nonproliferating lines. This finding could explain the rapid recovery of the bone marrow function after the suspension of vitamin A intake.
Biochemical analysis of cell cycle machinery indicated that vitamin A caused the accumulation of 2 key inhibitors of cyclin-dependent kinases, namely p21Cip1 and p27Kip1. These findings, along with the observed up-regulation of cyclin A and E contents, allowed us to conclude that the cell cycle block mainly occurs at the S→G2 phase transition.
In conclusion, our in vitro findings demonstrate the first direct antiproliferative effect of vitamin A on both hematopoietic and nonhematopoietic bone marrow components. The activity is rapidly reversible either in vitro or in vivo, thus indicating that no definitive damage is caused. We cannot rule out the possibility that vitamin A induces its in vivo effect, at least in part, through its derivatives and particularly through retinoic acid. However, because it has only recently been demonstrated that retinoic acid enhances the long-term repopulating of hematopoietic stem cells,31 we believe that the large part of the antiproliferative effects on bone marrow may be directly attributed to all-trans-retinol.
In this context, it is important to underline that vitamin D3 and its analogs are also able to inhibit the proliferation of blood cells by inducing the accumulation of cdk inhibitors,32 even if the effect of these compounds on the MSCs has not yet been investigated.
Understanding the possible toxicity associated with hypervitaminosis A becomes increasingly important in view of the popularity of vitamin A supplementation. The use of large doses of vitamin A in the care of skin conditions and in the possible prevention of cancer, the large use of megavitamin therapy in certain chronic disorders, and the growing tendency toward vitamin faddism should alert the physician to possible symptoms from vitamin overdose. The National Center of Health Statistics and the Food and Drug Administration found that approximately one fourth of the U.S. population and two thirds of users of vitamin supplements ingest products containing vitamin A. Furthermore, retinol is added to several foods, particularly those administered to infants and young children. With food faddism rampant in our society, it is possible that an increasing number of people (particularly children) have excess hepatic reserves of vitamin A and risk clinical vitamin A toxicity. Thus, clinicians should request dietary information and consider the diagnosis of hypervitaminosis A in any patient with unexplained signs and symptoms that may be consistent with this condition.
As illustrated in our case, the nutritional history may be important in evaluating an infant or child with anemia and thrombocytopenia.
Supported partly by grants from “Progetto di Ricerca di Ateneo” Seconda Università di Napoli, from Regione Campania FSR 86/87, from Associazione Italiana per la Ricerca sul Cancro (AIRC), and from MURST (Progetti di Rilevante Interesse Nazionale).
The publication costs of this article were defrayed in part by page charge payment. Therefore, and solely to indicate this fact, this article is hereby marked “advertisement” in accordance with 18 U.S.C. section 1734.
References
Author notes
Silverio Perrotta, Dipartimento di Pediatria, II Università di Napoli, Via S. Andrea delle Dame 4, 80138 Napoli, Italy; e-mail: silverio.perrotta@unina2.it.